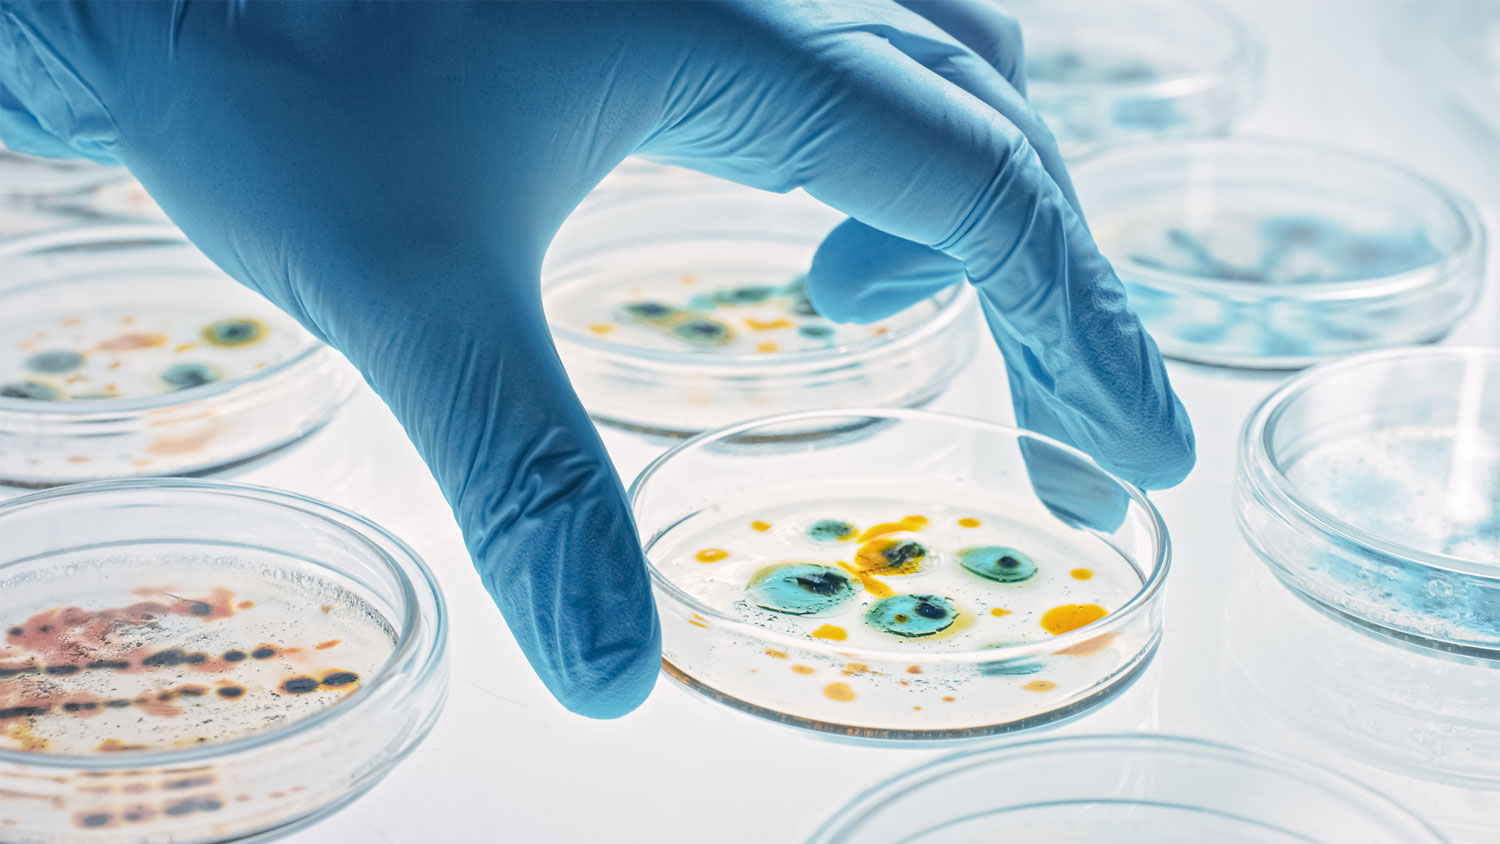

Understanding differences between academia and industrial biotech roles
Mon, 10/31/2022 - 12:00
To bolster Singapore’s growing biotech ecosystem, initiatives like SGInnovate’s Helix Immersion Programme have been designed to smoothen the transition for academics and researchers looking to take on industry roles. We speak with Dr Sashi Kesavapany, who draws on his personal experience across academia and industry to tell us more about how to avoid ‘culture shocks’ when professionals make this move.
After completing his PhD in neuroscience and two postdocs in the UK and US, Dr Sashi Kesavapany returned to Singapore for a faculty position at the National University of Singapore (NUS). For three years, as Assistant Professor, he focused on research in Alzheimer’s disease and Motor Neuron Disease, before moving on to a position at pharmaceutical giant GSK’s Neural Pathways Discovery Performance Unit.
Here, Dr Kesavapany found himself more directly involved in drug discovery to improve human health, working with a team looking for small molecule and biologic therapeutic intervention in the likes of Huntington’s disease, Spinal Muscular Atrophy and ALS (Motor neurone disease). “It was an exciting time, looking for targets and therapeutics to cure these horrible diseases,” he recalled.
As he describes it, the transition from academia to industry was both challenging and fulfilling. “You’re not doing blue-sky research anymore,” he explained. “You’re doing translational work that’s impacting human health… and that’s where I realised I wanted to be.”
But getting familiar with his new research areas entailed plenty of “reading and cramming”. “We really needed to know how to lead and contribute to the scientific teams in those areas,” said Dr Kesavapany, whose personal experience provides some answers for academics considering the switch to industry. “The learning curve is steep, but the mantra is always ‘patients first’.”
No pharmaceutical company will give you a drug discovery 101 course – you learn on the job. You get into a programme and learn everything from scratch.Dr Kesavapany on the steep learning curve faced in industry roles
More recently, he lent his industry knowledge to SGInnovate’s talent development efforts, leading the design and development of initiatives in the biomedical technology space. He lists key questions for researchers to consider:
- Do you wish to do work that has a more direct impact on medicine discovery, development and patient health?
- Are you willing to take a chance in an emerging industry and learn outside your comfort zone?
Navigating differences in objectives and perspectives
From greater job intensity to more interdisciplinary work, there are distinct differences between academia and industry.
According to Dr Kesavapany, one key difference between the two career tracks is the level of scientific rigour, with differences arising due to factors such as availability of funding and the impact of data utilisation in commercial drug discovery and development.
In addition to juggling the responsibilities of teaching, academic researchers and professors often face the pressures of ‘publish or perish’, motivating them to publish papers or patents quickly. In contrast, a researcher in an industry position faces distinctly different challenges. Industry research teams are required to observe a higher level of scientific rigour, to ensure that data is consistent and credible. In some cases, due to the nature of the company’s intellectual property (IP) stance, a programme may be placed in a no-publication position until the appropriate IP protections are in place.
Second, working in industry requires a broader perspective. While academia allows an individual to be laser-focused on one subject, like a mechanic that only specialises in repairing one brand of cars, industry pharmaceutical roles often require professionals to be well-versed across different areas of research and development.
“You might not need to know the ins and outs of specific functions like medicinal chemistry, but you have to understand how they come up with decisions (in that field),” observed Dr Kesavapany. “It’s about being able to contribute as a scientific leader in different areas and work in matrix team environments – which are common in pharma-level projects.”
Third, the biomedical sector’s fast-paced environment presents a steep learning curve – especially with multiple projects running concurrently. “No pharmaceutical company will give you a drug discovery 101 course – you learn on the job. You get into a programme and learn everything from scratch,” he noted.
Finally, the two tracks differ in objectives. Projects are largely grant-led in academia, allowing professors time to bring a project to fruition. Conversely, industry work is focused on optimising resources. “In industry, we’re pushed to kill projects – thus the concept of performing ‘killer experiments’,” he explained.
Combining knowledge from different disciplines
Academics certain of the move to industry must be prepared to work comfortably across different disciplines and tap on knowledge across multiple fields. This usually involves a need to hone certain attributes, such as versatility, and the willingness to switch research areas.
As industry often requires close collaboration with various experts such as chemists, biologists and analytical scientists, teamwork is also essential. “We’re not working in silos in this industry,” Dr Kesavapany pointed out. “This means you learn from other people in your matrix and programme teams.”
The ecosystem is getting to the point where there are going to be more biotechs coming online in the next one to five years… If you want to be closer to human health, products and therapeutics, this is something you’ll want to consider.Dr Kesavapany highlights key reasons for academics to expand their career perspectives through industry roles
Lastly, industry roles require a more critical eye when analysing published data. This helps them assess whether there is a need to replicate them in-house for confidence.
“Exploration is really key. You need to be open to learning about new diseases,” he said.
SGInnovate’s Helix Immersion Programme: Helping academics make the shift
Exciting career opportunities in this field beckon. As Prime Minister Lee Hsien Loong highlighted in his National Day Rally speech this year (2022), Singapore’s burgeoning biomedical sector contributes to almost a fifth of the country’s manufacturing gross domestic product and employs over 25,000 people.
Funding in the sector has also increased by more than five-fold in recent years, from S$120 million in 2016 to S$649 million in 2020. In 2021, local biomedical companies generated record funding, with S$820 million raised from January to September.
For academics that are keen to leverage these opportunities and expand their career perspectives, one initiative that can help smoothen the transition is SGInnovate’s Helix Immersion Programme (HIP). A year-long on-the-job training experience, it helps applicants from academic backgrounds gain industry experience through attachments to biomedical technology firms, where they receive close mentorship.
While industry roles – especially in startups – could raise concerns of job volatility, Dr Kesavapany noted that Singapore’s biotechs have proven to be largely stable and well-funded, giving professionals some peace of mind about having a job to grow in.
“The ecosystem is getting to the point where there are going to be more biotechs coming online in the next one to five years. The HIP is a proactive way of looking at how to bring talent into the scene,” said Dr Kesavapany.
“If you want to be closer to human health, products and therapeutics, this is something you’ll want to consider.”
If you’re a biomedical researcher / academic considering a role in industry, find out more about the Helix Immersion Programme on our website, or reach out to us for more details.
Trending Posts
- AI can fix your code, but it cannot fix bad architecture decisions
- Why some chip technologies make it to production - and others don't
- As space cybersecurity lifts off, talent and investment are key fuels
- The future of building inspections can’t stay manual. Meet the startup changing that.
- From satellites to startups, Singapore’s space sector is pushing new frontiers